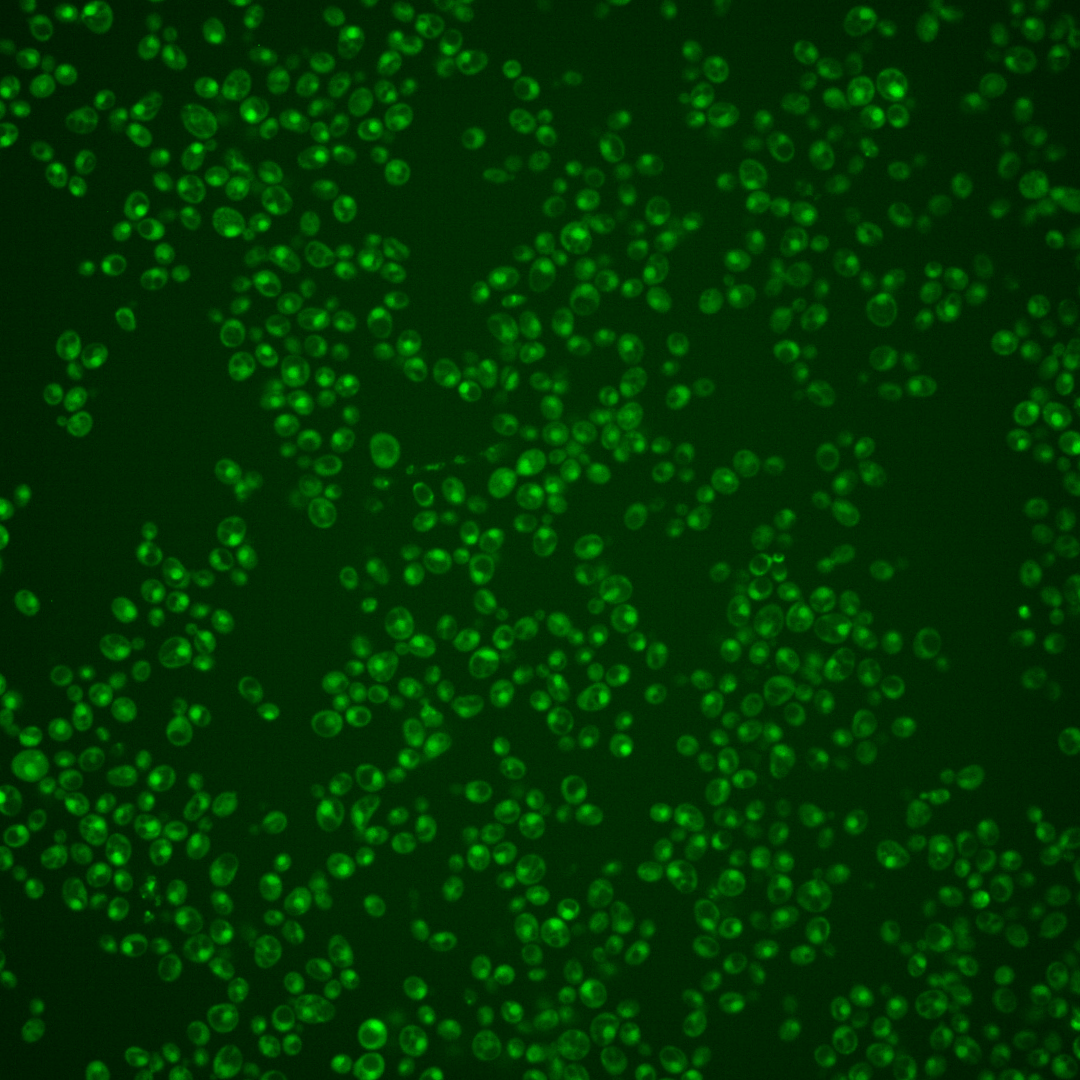
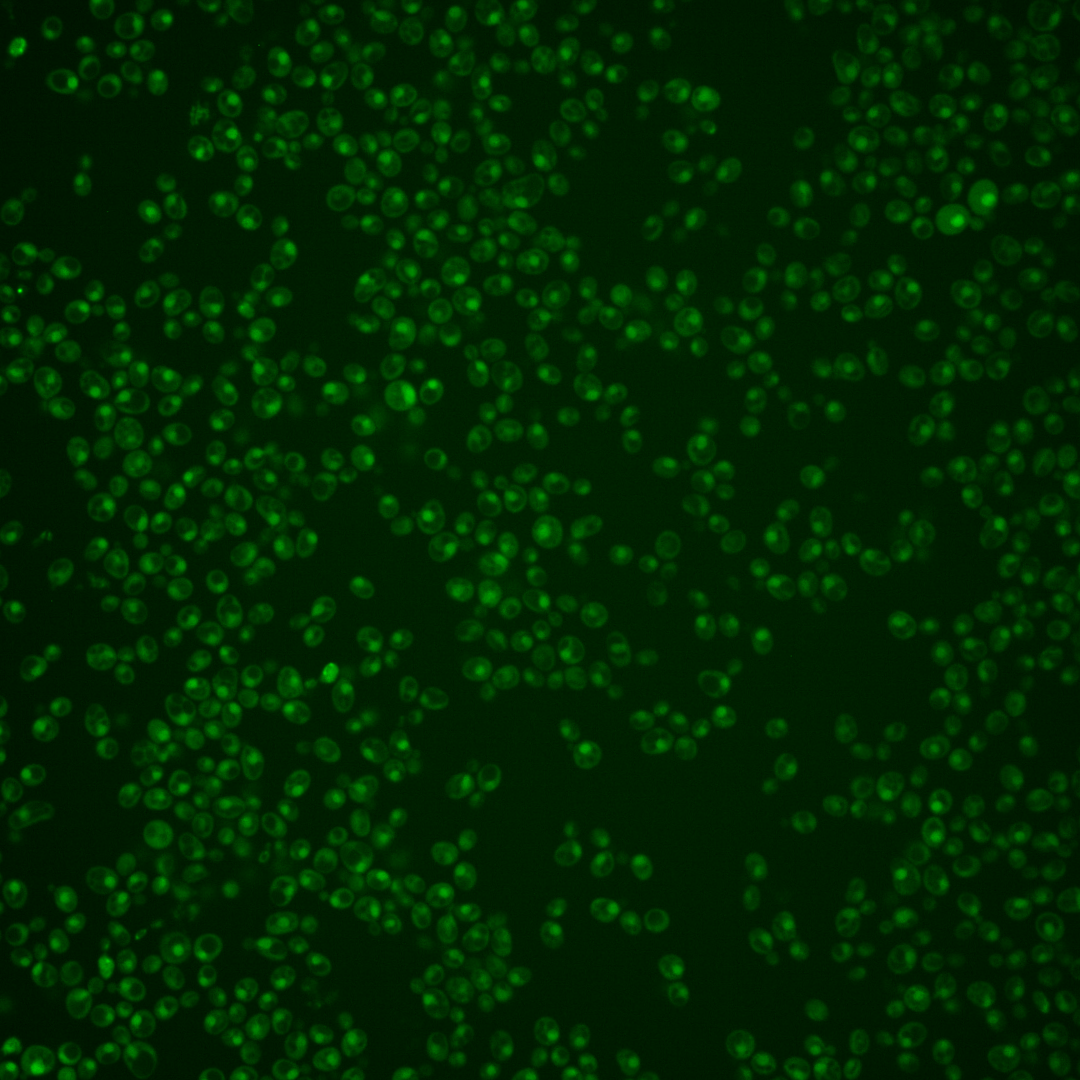
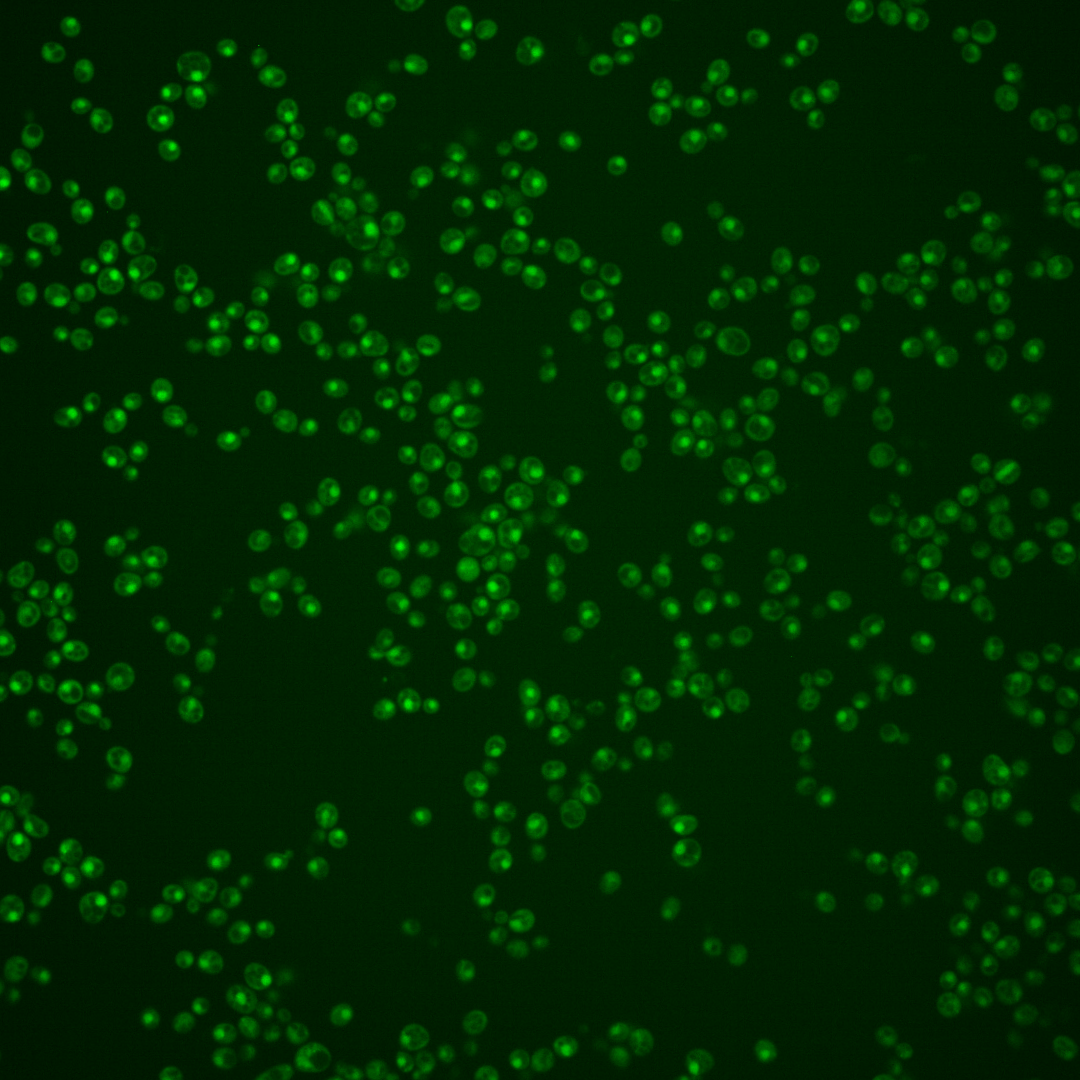
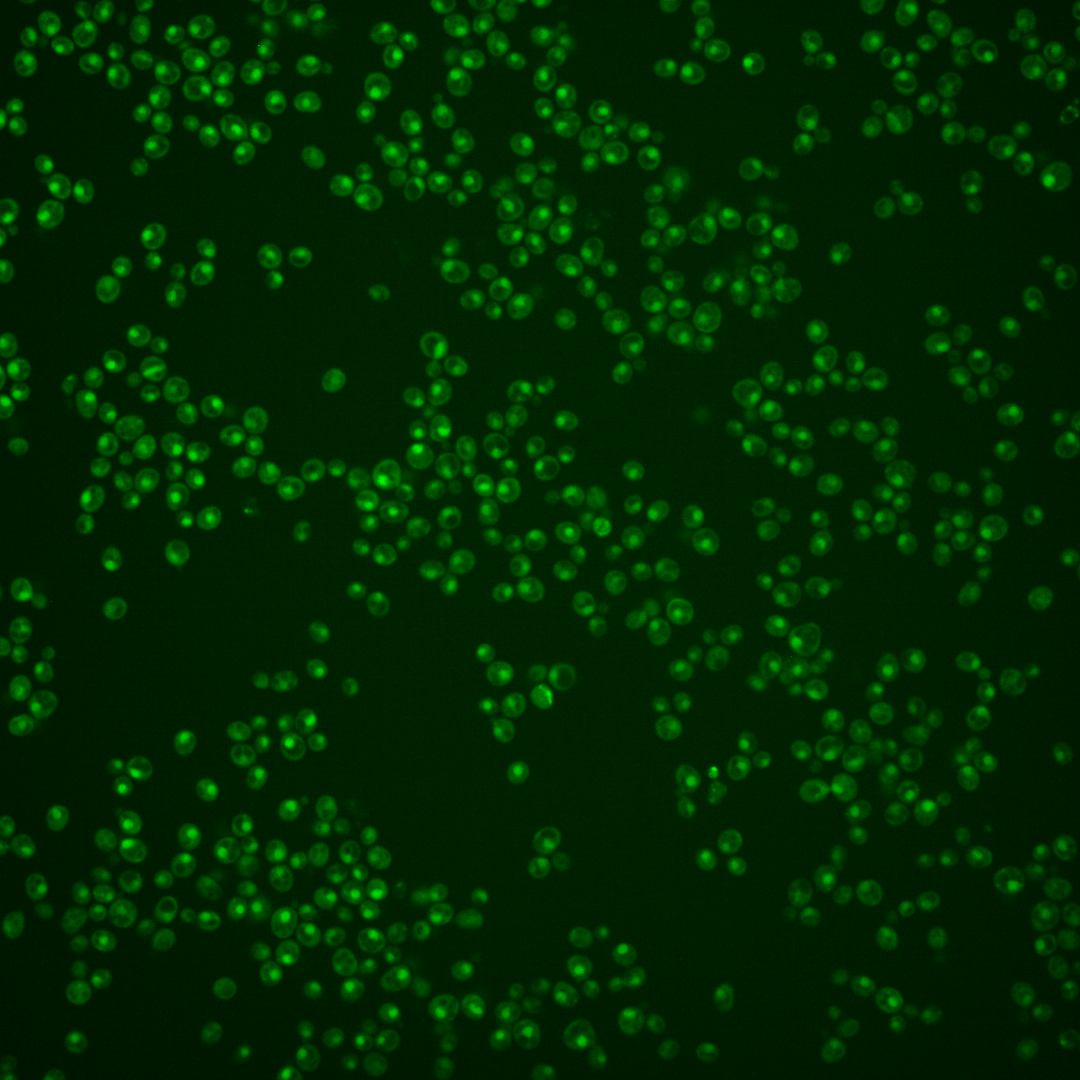
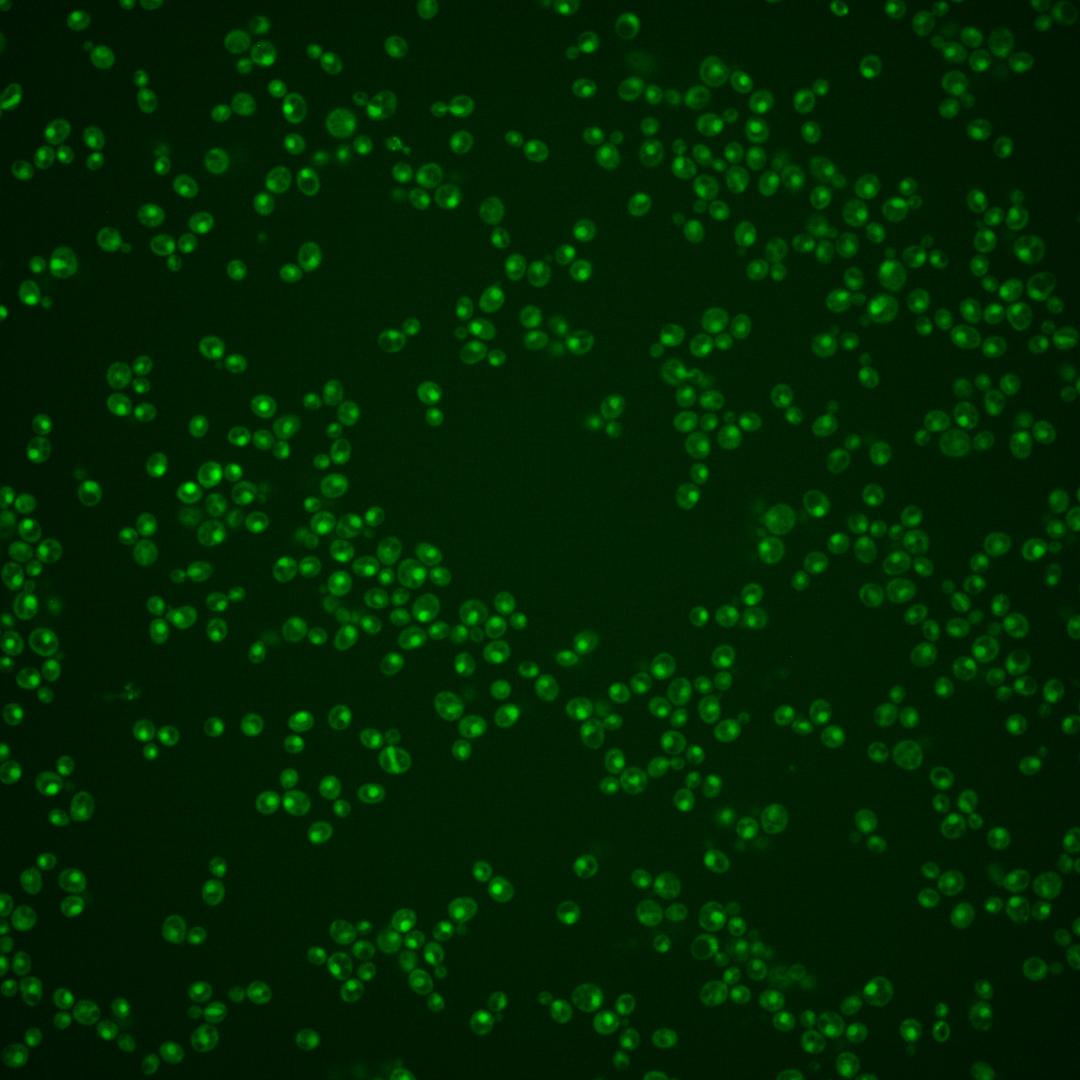

| Standard name | |
|---|---|
| Human Ortholog | |
| Description | Regulatory protein that binds Pdc2p and Thi2p transcription factors; activates thiamine biosynthesis transcription factors Pdc2p and Thi2p by binding to them, but releases and de-activates them upon binding to thiamine pyrophosphate (TPP), the end product of the pathway; has similarity to decarboxylases but enzymatic activity is not detected |
Micrographs




















































































Sub-cellular Localization
Yeast GFP Assignment
Protein Abundance
Localization Change
External localization resources
| ensLOC | DeepLoc | |||||||||||||||||||||||
|---|---|---|---|---|---|---|---|---|---|---|---|---|---|---|---|---|---|---|---|---|---|---|---|---|
| Localization | WT1 | WT2 | WT3 | RAP60 | RAP140 | RAP220 | RAP300 | RAP380 | RAP460 | RAP540 | RAP620 | RAP700 | HU80 | HU120 | HU160 | rpd3Δ_1 | rpd3Δ_2 | rpd3Δ_3 | WT1 | WT2 | WT3 | AF100 | AF140 | AF180 |
| Cortical Patches | 0 | 0 | 0 | 0 | 0 | 0 | 1 | – | 0 | 0 | 0 | 0 | – | – | – | 0 | 0 | 0 | 1 | 0 | 0 | 0 | 0 | 0 |
| Bud | 0 | 0 | 0 | 0 | 0 | 0 | 1 | – | 2 | 0 | 4 | 1 | – | – | – | 0 | 0 | 0 | 0 | 4 | 3 | 0 | 0 | 1 |
| Bud Neck | 1 | 0 | 0 | 0 | 0 | 0 | 0 | – | 1 | 0 | 0 | 1 | – | – | – | 0 | 0 | 0 | 0 | 1 | 0 | 0 | 0 | 0 |
| Bud Site | 0 | 0 | 0 | 0 | 0 | 1 | 1 | – | 5 | 1 | 3 | 3 | – | – | – | 0 | 0 | 0 | – | – | – | – | – | – |
| Cell Periphery | 0 | 0 | 0 | 0 | 0 | 0 | 0 | – | 0 | 0 | 0 | 0 | – | – | – | 0 | 0 | 0 | 0 | 0 | 0 | 0 | 0 | 0 |
| Cytoplasm | 26 | 18 | 10 | 7 | 26 | 47 | 55 | – | 28 | 29 | 45 | 34 | – | – | – | 29 | 26 | 27 | 8 | 5 | 6 | 1 | 4 | 2 |
| Endoplasmic Reticulum | 1 | 0 | 1 | 0 | 0 | 0 | 0 | – | 1 | 0 | 0 | 2 | – | – | – | 13 | 4 | 1 | 1 | 0 | 1 | 0 | 0 | 0 |
| Endosome | 4 | 3 | 0 | 4 | 2 | 2 | 6 | – | 3 | 0 | 1 | 0 | – | – | – | 3 | 2 | 2 | 0 | 3 | 1 | 1 | 0 | 1 |
| Golgi | 0 | 0 | 0 | 1 | 0 | 0 | 1 | – | 0 | 0 | 0 | 0 | – | – | – | 0 | 1 | 0 | 1 | 3 | 0 | 0 | 0 | 0 |
| Mitochondria | 45 | 4 | 2 | 3 | 6 | 29 | 30 | – | 81 | 68 | 177 | 69 | – | – | – | 12 | 4 | 6 | 5 | 1 | 0 | 0 | 0 | 0 |
| Nucleus | 244 | 330 | 153 | 79 | 71 | 58 | 71 | – | 68 | 70 | 78 | 53 | – | – | – | 159 | 138 | 133 | 273 | 320 | 142 | 1 | 2 | 0 |
| Nuclear Periphery | 0 | 0 | 0 | 0 | 0 | 0 | 0 | – | 0 | 0 | 1 | 0 | – | – | – | 0 | 0 | 0 | 1 | 0 | 0 | 0 | 0 | 0 |
| Nucleolus | 2 | 0 | 0 | 0 | 0 | 0 | 0 | – | 1 | 1 | 0 | 0 | – | – | – | 0 | 0 | 0 | 0 | 4 | 0 | 0 | 0 | 1 |
| Peroxisomes | 0 | 0 | 0 | 0 | 0 | 0 | 0 | – | 0 | 0 | 0 | 0 | – | – | – | 0 | 0 | 0 | 0 | 0 | 0 | 0 | 0 | 0 |
| SpindlePole | 1 | 0 | 0 | 0 | 2 | 1 | 1 | – | 2 | 1 | 0 | 1 | – | – | – | 0 | 0 | 1 | 3 | 2 | 2 | 0 | 1 | 1 |
| Vac/Vac Membrane | 17 | 37 | 2 | 9 | 13 | 27 | 29 | – | 13 | 15 | 19 | 14 | – | – | – | 46 | 34 | 31 | 29 | 38 | 31 | 1 | 4 | 0 |
| Unique Cell Count | 305 | 370 | 164 | 98 | 113 | 141 | 174 | 155 | 148 | 248 | 138 | 227 | 197 | 184 | 332 | 389 | 193 | 7 | 15 | 14 | ||||
| Labelled Cell Count | 341 | 392 | 168 | 103 | 120 | 165 | 196 | 205 | 185 | 328 | 178 | 262 | 209 | 201 | 332 | 389 | 193 | 7 | 15 | 14 | ||||
Yeast GFP Assignment
Protein Abundance
| Screen | WT1 | WT2 | WT3 | RAP60 | RAP140 | RAP220 | RAP300 | RAP380 | RAP460 | RAP540 | RAP620 | RAP700 | HU80 | HU120 | HU160 | rpd3Δ_1 | rpd3Δ_2 | rpd3Δ_3 | AF100 | AF140 | AF180 |
|---|---|---|---|---|---|---|---|---|---|---|---|---|---|---|---|---|---|---|---|---|---|
| Mean Cell GFP Intensity (1e-4) | 4.6 | 5.9 | 5.7 | 5.5 | 5.9 | 4.7 | 5.1 | – | 4.2 | 4.3 | 3.8 | 4.0 | – | – | – | 7.2 | 7.2 | 7.0 | – | – | – |
| Std Deviation (1e-4) | 1.0 | 0.9 | 1.1 | 1.5 | 1.5 | 1.3 | 1.4 | – | 1.4 | 1.4 | 0.7 | 0.9 | – | – | – | 1.0 | 1.2 | 1.2 | – | – | – |
| Intensity Change (Log2) | – | – | – | -0.05 | 0.03 | -0.28 | -0.18 | – | -0.43 | -0.4 | -0.59 | -0.52 | – | – | – | 0.33 | 0.33 | 0.29 | – | – | – |
Localization Change
| Localization | RAP60 | RAP140 | RAP220 | RAP300 | RAP380 | RAP460 | RAP540 | RAP620 | RAP700 | HU80 | HU120 | HU160 | rpd3Δ_1 | rpd3Δ_2 | rpd3Δ_3 |
|---|---|---|---|---|---|---|---|---|---|---|---|---|---|---|---|
| Cortical Patches | 0 | 0 | 0 | 0 | – | 0 | 0 | 0 | 0 | – | – | – | 0 | 0 | 0 |
| Bud | 0 | 0 | 0 | 0 | – | 0 | 0 | 0 | 0 | – | – | – | 0 | 0 | 0 |
| Bud Neck | 0 | 0 | 0 | 0 | – | 0 | 0 | 0 | 0 | – | – | – | 0 | 0 | 0 |
| Bud Site | 0 | 0 | 0 | 0 | – | 0 | 0 | 0 | 0 | – | – | – | 0 | 0 | 0 |
| Cell Periphery | 0 | 0 | 0 | 0 | – | 0 | 0 | 0 | 0 | – | – | – | 0 | 0 | 0 |
| Cytoplasm | 0.3 | 4.1 | 6.1 | 5.9 | – | 3.3 | 3.6 | 3.5 | 4.5 | – | – | – | 2.2 | 2.2 | 2.6 |
| Endoplasmic Reticulum | 0 | 0 | 0 | 0 | – | 0 | 0 | 0 | 0 | – | – | – | 2.7 | 0 | 0 |
| Endosome | 0 | 0 | 0 | 0 | – | 0 | 0 | 0 | 0 | – | – | – | 0 | 0 | 0 |
| Golgi | 0 | 0 | 0 | 0 | – | 0 | 0 | 0 | 0 | – | – | – | 0 | 0 | 0 |
| Mitochondria | 0 | 0 | 0 | 5.0 | – | 0 | 0 | 0 | 0 | – | – | – | 2.1 | 0 | 0 |
| Nucleus | -3.1 | -6.3 | -9.8 | -10.2 | – | -9.6 | -9.0 | -12.4 | -10.2 | – | – | – | -5.6 | -5.6 | -5.1 |
| Nuclear Periphery | 0 | 0 | 0 | 0 | – | 0 | 0 | 0 | 0 | – | – | – | 0 | 0 | 0 |
| Nucleolus | 0 | 0 | 0 | 0 | – | 0 | 0 | 0 | 0 | – | – | – | 0 | 0 | 0 |
| Peroxisomes | 0 | 0 | 0 | 0 | – | 0 | 0 | 0 | 0 | – | – | – | 0 | 0 | 0 |
| SpindlePole | 0 | 0 | 0 | 0 | – | 0 | 0 | 0 | 0 | – | – | – | 0 | 0 | 0 |
| Vacuole | 0 | 3.7 | 5.3 | 4.9 | – | 3.0 | 3.5 | 2.9 | 3.4 | – | – | – | 5.7 | 5.1 | 5.0 |
External localization resources
Images






























Protein Concentration and Protein Localization Data
| R1 | R2 | R3 | ||||||||||||||||
|---|---|---|---|---|---|---|---|---|---|---|---|---|---|---|---|---|---|---|
| G1 Pre-START | G1 Post-START | S/G2 | Metaphase | Anaphase | Telophase | G1 Pre-START | G1 Post-START | S/G2 | Metaphase | Anaphase | Telophase | G1 Pre-START | G1 Post-START | S/G2 | Metaphase | Anaphase | Telophase | |
| Concentration | 0.9739 | 0.5863 | 0.7653 | 0.2454 | 0.753 | 0.4578 | 0.2224 | 0.6352 | 0.4625 | 0.2909 | 0.0654 | 0.4548 | 0.8952 | 0.7767 | 0.6614 | 0.5872 | 0.373 | 0.7001 |
| Actin | 0.0153 | 0.0001 | 0.0087 | 0 | 0.0051 | 0.0013 | 0.0063 | 0.0002 | 0.0001 | 0.0004 | 0.0002 | 0.0001 | 0.038 | 0.0001 | 0.0207 | 0.0075 | 0.0001 | 0.0159 |
| Bud | 0.002 | 0 | 0.0005 | 0 | 0.0006 | 0.0002 | 0.0001 | 0.0001 | 0 | 0.0003 | 0 | 0 | 0.0007 | 0.0009 | 0.0004 | 0.0006 | 0 | 0.0001 |
| Bud Neck | 0.0073 | 0.0002 | 0.0055 | 0.0001 | 0.0352 | 0.0015 | 0.0008 | 0.0004 | 0.0002 | 0.0056 | 0.0006 | 0.001 | 0.0061 | 0.0002 | 0.0079 | 0.0006 | 0.0013 | 0.0014 |
| Bud Periphery | 0.0034 | 0 | 0.0006 | 0 | 0.0008 | 0.0007 | 0.0002 | 0.0001 | 0 | 0.0006 | 0 | 0 | 0.0013 | 0.0001 | 0.0006 | 0.0008 | 0 | 0.0003 |
| Bud Site | 0.0153 | 0.0002 | 0.0059 | 0 | 0.0076 | 0.0002 | 0.0002 | 0.0006 | 0.0001 | 0.0111 | 0.0001 | 0.0001 | 0.0062 | 0.0013 | 0.0123 | 0.0151 | 0.0002 | 0.0002 |
| Cell Periphery | 0.001 | 0 | 0.0002 | 0 | 0.0003 | 0.0001 | 0 | 0 | 0 | 0.0005 | 0 | 0 | 0.0004 | 0 | 0.0002 | 0.0002 | 0 | 0.0001 |
| Cytoplasm | 0.0163 | 0.0219 | 0.0146 | 0.0039 | 0.01 | 0.0026 | 0.0076 | 0.0255 | 0.0081 | 0.0047 | 0.0601 | 0.0068 | 0.0146 | 0.0158 | 0.0113 | 0.0099 | 0.0128 | 0.0089 |
| Cytoplasmic Foci | 0.0235 | 0.0007 | 0.0205 | 0.0001 | 0.0349 | 0.0054 | 0.0016 | 0.0007 | 0.0004 | 0.0017 | 0.0024 | 0.0003 | 0.0168 | 0.0025 | 0.0028 | 0.005 | 0.0003 | 0.0026 |
| Eisosomes | 0.0002 | 0 | 0.0001 | 0 | 0.0001 | 0 | 0.0003 | 0 | 0 | 0.0001 | 0 | 0 | 0.0003 | 0 | 0.0001 | 0.0002 | 0 | 0.0002 |
| Endoplasmic Reticulum | 0.0042 | 0.0009 | 0.0022 | 0.0001 | 0.0007 | 0.0008 | 0.0005 | 0.0007 | 0.0004 | 0.0004 | 0.0029 | 0.0002 | 0.0035 | 0.0003 | 0.0005 | 0.0015 | 0.0014 | 0.0013 |
| Endosome | 0.0412 | 0.001 | 0.0218 | 0 | 0.0353 | 0.006 | 0.0022 | 0.0007 | 0.0005 | 0.0024 | 0.002 | 0.0003 | 0.0265 | 0.0002 | 0.0088 | 0.0062 | 0.0016 | 0.0067 |
| Golgi | 0.0105 | 0 | 0.0126 | 0 | 0.0256 | 0.0023 | 0.0006 | 0 | 0 | 0.0003 | 0 | 0 | 0.0122 | 0 | 0.0023 | 0.0022 | 0 | 0.0023 |
| Lipid Particles | 0.0166 | 0.0002 | 0.0179 | 0 | 0.013 | 0.003 | 0.0043 | 0.0002 | 0.0001 | 0.0006 | 0.0003 | 0 | 0.0104 | 0.0002 | 0.0022 | 0.0066 | 0.0001 | 0.0019 |
| Mitochondria | 0.0115 | 0.0003 | 0.0151 | 0.0002 | 0.0091 | 0.0082 | 0.0021 | 0.0004 | 0.0003 | 0.0011 | 0.0003 | 0.0002 | 0.0145 | 0.0003 | 0.0073 | 0.0023 | 0.0003 | 0.0039 |
| None | 0.0325 | 0.0447 | 0.026 | 0.038 | 0.0488 | 0.016 | 0.0182 | 0.0561 | 0.0348 | 0.0121 | 0.0277 | 0.0384 | 0.013 | 0.0382 | 0.0255 | 0.0033 | 0.0017 | 0.0133 |
| Nuclear Periphery | 0.0235 | 0.0154 | 0.0154 | 0.0021 | 0.008 | 0.0126 | 0.0069 | 0.009 | 0.0078 | 0.0052 | 0.0196 | 0.0037 | 0.0173 | 0.0053 | 0.0115 | 0.0407 | 0.009 | 0.0136 |
| Nucleolus | 0.0147 | 0.006 | 0.0079 | 0.0042 | 0.016 | 0.0134 | 0.0063 | 0.0075 | 0.0072 | 0.0098 | 0.0077 | 0.0122 | 0.0082 | 0.0046 | 0.0044 | 0.0056 | 0.0074 | 0.0077 |
| Nucleus | 0.6799 | 0.8734 | 0.7806 | 0.9486 | 0.6783 | 0.8934 | 0.9238 | 0.8744 | 0.9237 | 0.8929 | 0.8446 | 0.9198 | 0.772 | 0.9156 | 0.8687 | 0.878 | 0.9531 | 0.8837 |
| Peroxisomes | 0.0145 | 0 | 0.0076 | 0 | 0.0449 | 0.0028 | 0.0057 | 0.0001 | 0 | 0.0006 | 0.0001 | 0 | 0.0117 | 0.0001 | 0.0062 | 0.0052 | 0 | 0.0026 |
| Punctate Nuclear | 0.0375 | 0.0339 | 0.0316 | 0.0027 | 0.0198 | 0.0265 | 0.0113 | 0.0221 | 0.0159 | 0.0467 | 0.0303 | 0.0167 | 0.0207 | 0.013 | 0.0028 | 0.0072 | 0.0097 | 0.0293 |
| Vacuole | 0.0216 | 0.0008 | 0.003 | 0.0001 | 0.0047 | 0.0015 | 0.0008 | 0.0009 | 0.0002 | 0.0026 | 0.0008 | 0.0002 | 0.0042 | 0.001 | 0.0029 | 0.0009 | 0.0007 | 0.0023 |
| Vacuole Periphery | 0.0073 | 0.0002 | 0.0018 | 0 | 0.0012 | 0.0015 | 0.0003 | 0.0002 | 0.0001 | 0.0003 | 0.0003 | 0.0001 | 0.0015 | 0.0002 | 0.0009 | 0.0006 | 0.0002 | 0.0014 |
Sequencing Data
| R1 | R2 | |||||||||
|---|---|---|---|---|---|---|---|---|---|---|
| G1 Post-START | S/G2 | Metaphase | Anaphase | Telophase | G1 Post-START | S/G2 | Metaphase | Anaphase | Telophase | |
| Gene Expression | 7.2354 | 5.39 | 9.5991 | 9.6152 | 9.7719 | 3.0131 | 10.2185 | 12.3223 | 10.1762 | 10.9632 |
| Translational Efficiency | 0.345 | 0.799 | 0.2926 | 0.2652 | 0.3098 | 1.0405 | 0.3432 | 0.2817 | 0.3575 | 0.309 |
Hit Data
| Dataset | Hit |
|---|---|
| Protein Concentration | ✘ |
| Protein Localization | ✘ |
| Gene Expression | ✘ |
| Translational Efficiency | ✘ |
Endocytosis
| Temp | Actin Patch (Sac6-tdTomato) | Cortical Patch (Sla1-GFP) | Late Endosome (Snf7-GFP) | Vacuole (Vph1-GFP) |
|---|---|---|---|---|
| 37℃ | ||||
| RT |
Cell Cycle Omics
CYCLoPs (Thi3-GFP)
| Gene / Allele | Actin Patch (Sac6-tdTomato) | Cortical Patch (Sla1-GFP) | Late Endosome (Snf7-GFP) | Vacuole (Sac6-tdTomato) |
|---|
| Gene | Images |
|---|
| Gene | Images |
|---|
Images are not yet available
Images are not yet available